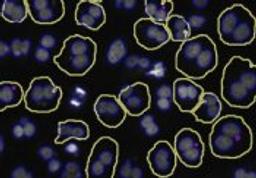

Micronucleus V2 Image Analysis BioApplication for Genotoxicity
The Micronucleus V2 BioApplication is a powerful image analysis algorithm for identifying and quantitating the rare event of micronucleus formation as a measure of genotoxicity. Because it can screen a 96-well plate in under 8 hours, it enables screening for genotoxic compounds in an automated, objective manner. This application has been biologically validated, enhancing confidence in your image-based data. Available for th…
The Micronucleus V2 BioApplication is a powerful image analysis algorithm for identifying and quantitating the rare event of micronucleus formation as a measure of genotoxicity. Because it can screen a 96-well plate in under 8 hours, it enables screening for genotoxic compounds in an automated, objective manner.
This application has been biologically validated, enhancing confidence in your image-based data. Available for the Cellomics ArrayScan VTI, ArrayScan x.5, and KineticScan platforms.